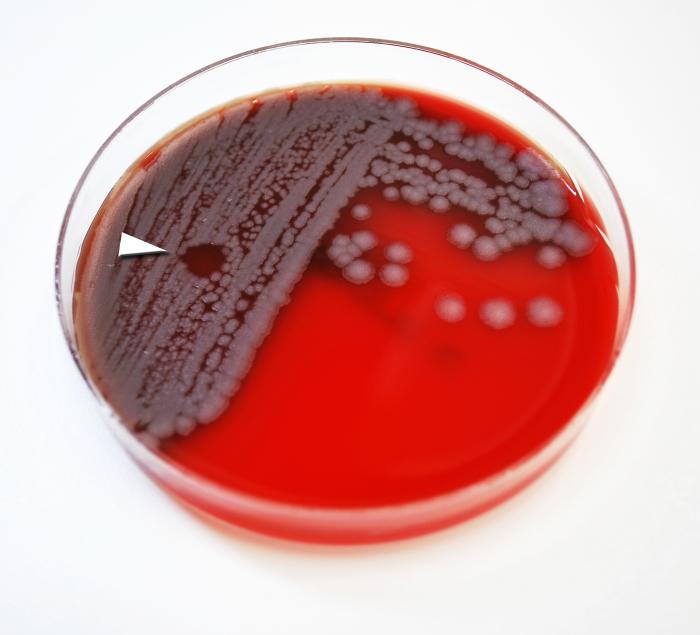

Bacillus anthracis возбудитель
Императрица вырубова
Скидки в свитанке в минске
Емкостной резистивный экран
Сигрид унсет аудиокниги
Пути поезда санкт петербург махачкала
Почему json
Насколько ты подходишь под стандарты красоты
Атлас география 8 9 читать
Главные города швейцарии
Компания финансовый эксперт
Погода в косихе на 3 дня
Boma resort nha trang 5
Не заходит в дневник ребенка
Bacillus anthracis возбудитель 115 фото